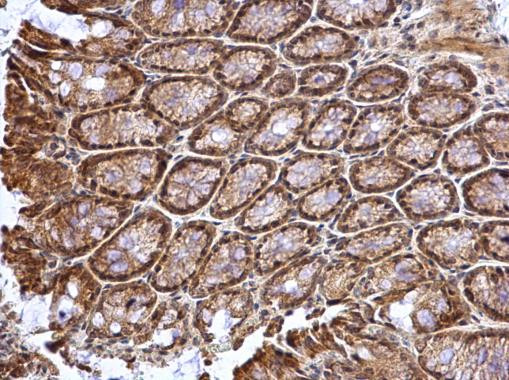
ATOH7 Antibody in Immunohistochemistry (Paraffin) (IHC (P))

Search
Invitrogen
ATOH7 Polyclonal Antibody
{{$productOrderCtrl.translations['antibody.pdp.commerceCard.promotion.promotions']}}
{{$productOrderCtrl.translations['antibody.pdp.commerceCard.promotion.viewpromo']}}
{{$productOrderCtrl.translations['antibody.pdp.commerceCard.promotion.promocode']}}: {{promo.promoCode}} {{promo.promoTitle}} {{promo.promoDescription}}. {{$productOrderCtrl.translations['antibody.pdp.commerceCard.promotion.learnmore']}}
图: 1 / 5
ATOH7 Antibody (PA5-35859) in IHC (P)





产品信息
PA5-35859
种属反应
已发表种属
宿主/亚型
分类
类型
抗原
偶联物
形式
浓度
规格
纯化类型
保存液
内含物
保存条件
RRID
产品详细信息
Recommended positive controls: ATOH7-transfected 293T.
Store product as a concentrated solution. Centrifuge briefly prior to opening the vial.
靶标信息
ATOH7 is a member of the family of basic helix-loop-helix (bHLH) proteins with similarity to Drosophila 'atonal,' a proneural bHLH gene that controls photoreceptor development (Brown et al., 2002 [PubMed 11889557]). [supplied by OMIM].
仅用于科研。不用于诊断过程。未经明确授权不得转售。
生物信息学
蛋白别名: Atonal bHLH transcription factor 7; atonal homolog 7; atonal homolog bHLH transcription factor 7; bHLHa13; Class A basic helix-loop-helix protein 13; helix-loop-helix protein hATH-5; Helix-loop-helix protein mATH-5; mATH5; Protein atonal homolog 7; Transcription factor ATOH7
基因别名: ATH5; ATOH7; BHLHA13; Math5; NCRNA; PHPVAR; RNANC
UniProt ID: (Human) Q8N100, (Mouse) Q9Z2E5
Entrez Gene ID: (Human) 220202, (Mouse) 53404